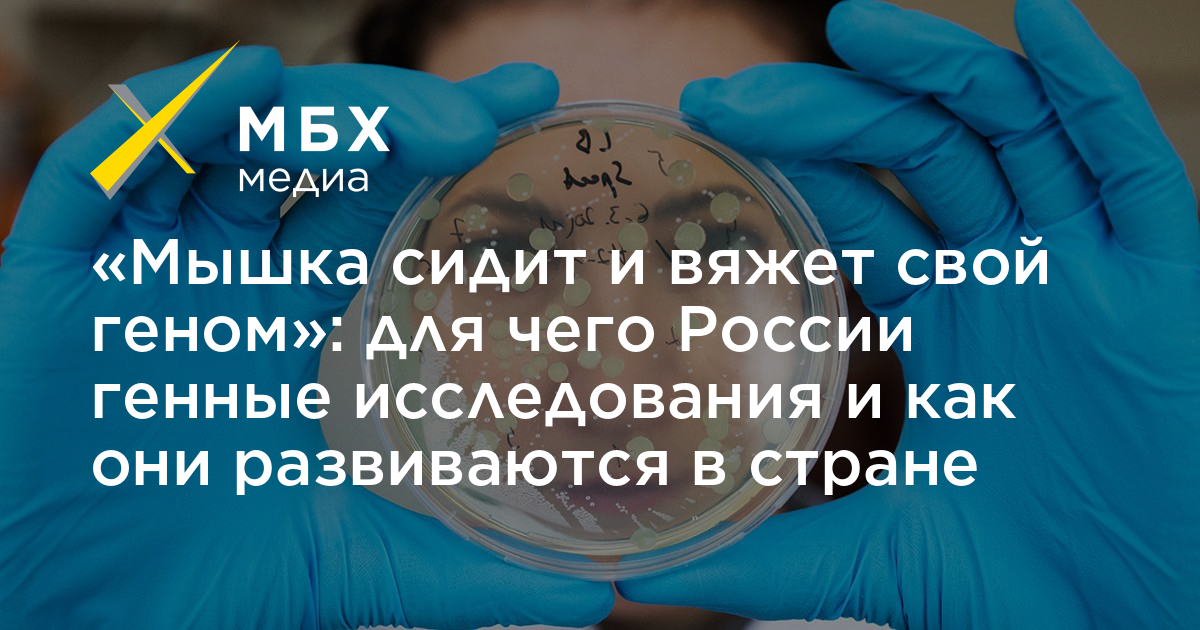

«Мышка сидит и вяжет свой геном»: для чего России генные исследования и как они развиваются в стране
Владимир Путин увлекся развитием генных технологий. Уже почти два года в России в рамках нацпроекта создается новая инфраструктура для генных инженеров. За это время в стране решили делать большой центр по хранению генетических данных, ученые участвуют в разработке вакцины от коронавируса, а в МГУ готовится к открытию магистерская программа для генетиков. Рассказываем, как развиваются генные технологии в России, и при чем тут «Роснефть», «дочка Путина» и клетки Анастасии Заворотнюк.
«Роснефть» за хорошие гены
Генетика в России развивается в рамках нацпроекта «Наука», который запустили в 2018 году. Ключевым партнером по развитию генных исследований стала «Роснефть» — компания участвует в создании новой магистерской программы в МГУ, «Геномика и здоровье человека».
Обучение на этой программе связано с работой в проектах «Роснефти». У корпорации есть аффилированная некоммерческая организация «Развитие генетических технологий», в которой студенты будут проходить практику и защищать диссертации по ее проектам. Бюджетных мест на этой программе нет, но студентам обещают выплачивать стипендию — 50 тысяч рублей в месяц.
BBC предполагала, что курировать проект сможет Мария Воронцова — СМИ называют ее дочкой Путина. Девушка тоже занимается генетическими исследованиями и состоит в «Российской ассоциации содействия науке». Документально эта связь пока никак не подтверждается.

Глава корпорации Игорь Сечин говорит, что главный проект на начальном этапе — подготовка биотехнологического кампуса. Пока что он будет располагаться в институте биоорганической химии на юго-западе Москвы, а его приоритетом будут генетические обследования работников «Роснефти» и членов их семей. Инвестиции в генетические технологии Сечин просит налогами не облагать.
Геномный центр
За год в России построили три геномных центра «мирового уровня». Все находятся в Москве и области — в поселке Оболенское под Серпуховом находится «Центр биобезопасности», где изучают бактерии и микроорганизмы, а в московском институте имени Энгельгардта разрабатывают «очеловеченных мышей» — животных с частью человеческого генетического кода. «Мышкам лабораторным поставлен памятник в Новосибирске – мышка сидит и вяжет свой геном», — рассказывал в мае Путину директор научного центра Александр Макаров.
Помимо этого, в московском центре готовят вирусы, которые могут бороться с раковыми клетками — по словам директора института на совещании у Путина, этот вирус тестируют на клетках раковой опухоли актрисы Анастасии Заворотнюк. На базе Курчатовского института в Москве разрабатывают бактерии для нужд сельского хозяйства.

В Курчатовском институте появится и центр хранения генетических данных — такое поручение подписал Владимир Путин. Место выбрали потому, что в институте есть дата-центр, с помощью которого ученые смогут обмениваться информацией. В центре будет не только генетическая информация, но и биологические образцы — пока непонятно, какие.
Базы данных с генетической информацией есть во многих странах мира, с их помощью исследуют предрасположенность людей к определенным заболеваниям и разрабатывают соответствующие терапии и препараты. Крупнейшие проекты находятся в Великобритании, где хранятся 6 миллионов образцов ДНК, и в Исландии, где есть ДНК-профили всего населения страны — 300 тысяч человек.
Генетики в спортивном суде
Путин оценивает работу генетиков по расшифровке генетического кода в том числе и в делах, связанных со спортом. В институт Энгельгардта обратились адвокаты российского биатлониста Евгения Устюгова — в феврале его дисквалифицировали и лишили медалей олимпиады в Сочи за допинг.
Генетики проанализировали гены спортсмена и его родителей и нашли три гена, которые повышают уровень гемоглобина. По словам руководителя института, эти данные предоставят в спортивном арбитражном суде — они могут разрушить обвинение.